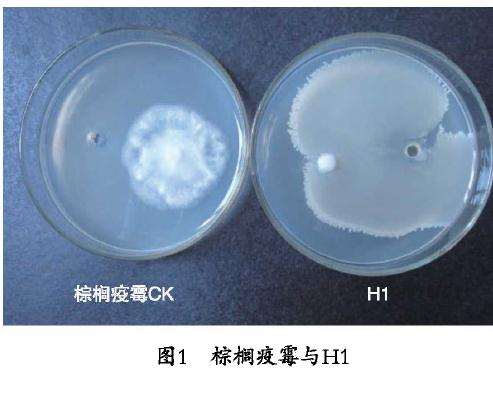
对番木瓜疫病室内盆栽防效试验的生防作用
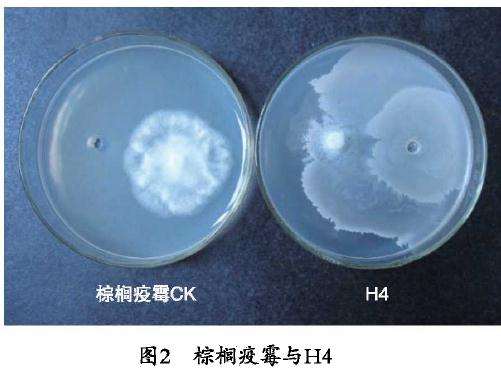
对番木瓜疫病室内盆栽防效试验的生防作用

对番木瓜疫病室内盆栽防效试验的生防作用
2020-06-01
19
核心提示:番木瓜疫病室内盆栽防效试验结果表明,H1与H4菌株均可起到一定的抑制番木瓜疫病病原菌的效果(图5—9)。接种H1与病原菌混合菌液的组培苗病情指数,辣椒疫霉为77.87和棕榈疫霉为83.33,高于接种H4与病原菌混合菌液的组培苗病情指数66.67和61.11。
1拮抗细菌的分离与筛选
从土壤样品中共分离出细菌分离物29个(H1 ̄H9,B1 ̄B10,P1 ̄P10)〇初筛结果表明,H1、H2、H4、H6、H7、H9、PI、P2和P4等9个菌株对辣椒疫霉抑菌率均高达100%,而HI、H4、H6、H9等4个菌株对棕榈疫霉抑菌率达100%(表2—3)〇二次筛选结果显示,H1和H42个菌株无论对棕榈疫霉还是辣椒疫霉均呈现极显著的拮抗效果(图1一4)。
2幼茎针刺接种法对番木瓜疫病室内盆栽防效试验的生防作用
番木瓜疫病室内盆栽防效试验结果表明,H1与H4菌株均可起到一定的抑制番木瓜疫病病原菌的效果(图5—9)。接种H1与病原菌混合菌液的组培苗病情指数,辣椒疫霉为77.87和棕榈疫霉为83.33,高于接种H4与病原菌混合菌液的组培苗病情指数66.67和61.11。

由此可推论出,H4菌株对辣椒疫霉和棕榈疫霉的防效要高于H1菌株。实际防效结果也表明,H1菌株对辣椒疫霉和棕榈疫霉的防效分别为15.15%和16.67%,低于H4菌株辣椒疫霉防效(27.27%)和棕榈疫霉防效(38.89%)(表4)。

试验结果表明,菌株H1和H4在平板对峙试验中呈现出对辣椒疫霉和棕榈疫霉的明显拮抗效果,但在用H1和H4菌株进行番木瓜室内盆栽防效试验时,实际生防效果较低,最高只达38.89%。由于本试验在室内盆栽实验中采用了“幼茎针刺接种法”,且在实验室中仅营造适宜番木瓜疫病发生的温度与湿度环境,并未考虑生防菌与病原菌感染过程以及实际环境变化造成的病原菌生长抑制等因素,造成实验生物防治效果偏低。

本试验从多个土壤样品中筛选得出了对番木瓜疫病病原菌具有强抑菌作用的菌株,今后可加大对黄埔土壤的研究,为生防建立一定的基础。本研究筛选菌株对病原菌抑菌机理,以及相关菌株对病原菌生防效果有待进一步更系统、全面地研究。
